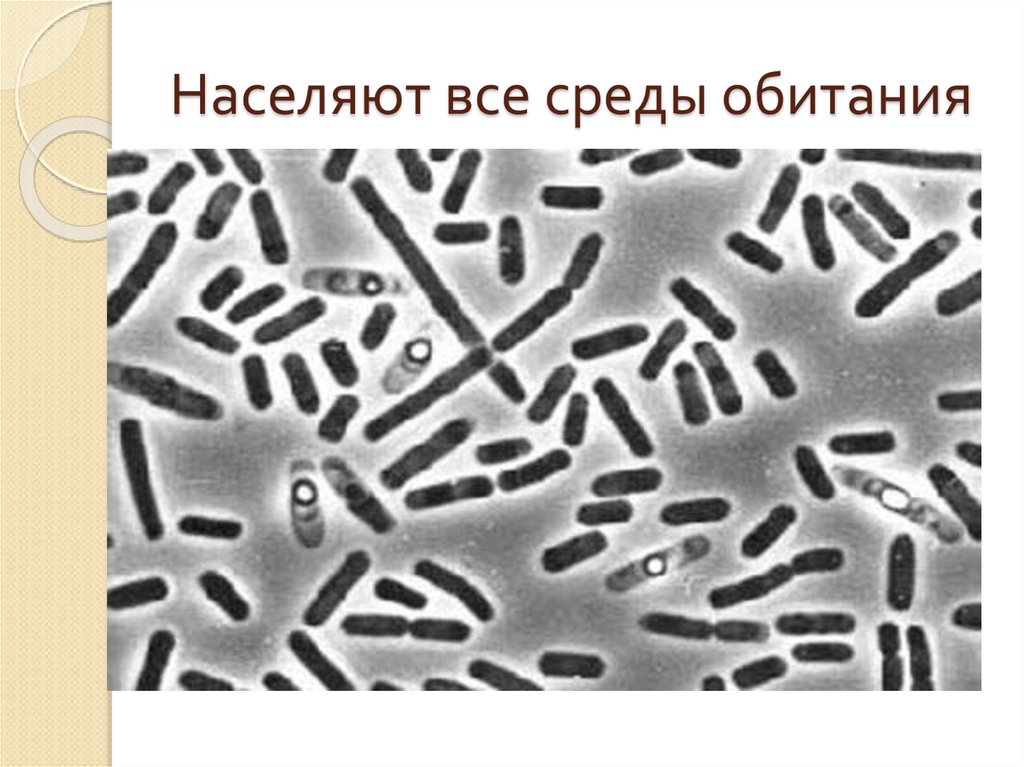
Населяют все среды обитания

Похожие презентации:
бактерии и вирусы
1. ВИРУСЫ- граница живой и неживой природы
ВИРУСЫграница живой инеживой
природы
2. Назовите признаки живого организма
ПитаетсяРастет
Дышит
обмен веществами
с окружающей средой
Размножается
Обладает изменчивостью
Передает наследственную информацию
3.
Вирус – кто или что,существо или
вещество?
4. ВИРУСЫ-неклеточная форма жизни
Способны жить и размножатьсятолько внутри организма- носителя!
Во внешнем мире существуют в
кристаллической форме, ожидая
своего носителя
5. Вирусы
Нанометр –10-9 метра
В 100 раз меньше
бактерий
От 10 до 275 нм
6. СТРОЕНИЕ ВИРУСОВ
7.
8.
Сравнение строения клетки бактерий,растительной клетки и вируса.
Органоиды
Клеточная
оболочка
Цитоплазма
Ядро
Хлоропласты
Клетка
бактерий
Клетка
растения
Вирус
9. Вызывают опасные заболевания!
Грипп, корь, свинка, СПИД, бешенство10. Заболевания растений:
Вирус мозаики и заболеваниежелтуха11. Борьба с вирусами
Профилактика вирусных заболеваний2) Лечение вирусных заболеваний
лекарствами
3) Удаление больных растений
1)
12. Бактерии- Одноклеточные организмы
13. Доядерные организмы-в клетках отсутствует ядро, есть ядерная область
14. Разнообразие бактерий
ШаровидныеКоккиВытянутыеПалочки, бациллы
ИзвитыеСпириллы
Есть подвижные и не
подвижные, живущие
группами и одиночно
15. Населяют все среды обитания
16. Размножение бактерий
Делением клетки пополам.при неблагоприятных
условиях образуют
споры- покоящуюся
стадию
17. Значение бактерий
1)Вызывают опасные заболевания:туберкулез, тиф, холера, дифтерит
18. 2)Используются человеком
-Молочнокислые бактерии- дляизготовления кисломолочной продукции и
квашеной капусты
-уксуснокислые бактерии-превращают
вино в уксус

Биология
Биология








